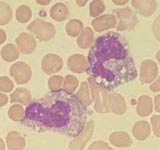
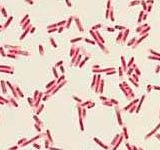
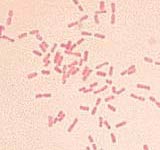
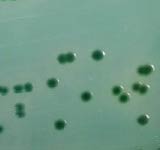

|

 |
 |
Artigo
Higiene de alimentos
Parte III: Toxi-infec?es alimentares
|
::: 12/07/2003
Muitas s?o as doen?as que podem ser transmitidas aos seres humanos atrav?s
de alimentos contaminados, quando pr?ticas de higiene s?o negligenciadas ou
esquecidas. O perigo das contamina?es por microorganismo ? t?o grande
quanto o perigo que existe no uso dos conservantes e outras subst?ncias que
s?o adicionadas aos alimentos durante o processamento industrial (os
chamados aditivos qu?micos) quando n?o respeitadas as regras espec?ficas de
utiliza??o dos mesmos. Observa-se muita preocupa??o, por grande parte da
popula??o, quanto ao risco desses aditivos nos alimentos industrializados,
mas pouca preocupa??o com a higiene e a conserva??o dos alimentos em
geral.
Mostramos, abaixo, alguns dos principais microorganismos que podem
ser transmitidos atrav?s dos alimentos, causadores das chamadas
"toxi-infec?es alimentares".
|
Staphylococcus aureus:
 Habitat: pele, nariz, garganta, cabelo, ferida com pus e espinhas.
Contamina??o: m?os n?o lavadas, tossir ou espirrar sobre os alimentos, uso
de panos (de prato ou outros na cozinha) contaminados.
Habitat: pele, nariz, garganta, cabelo, ferida com pus e espinhas.
Contamina??o: m?os n?o lavadas, tossir ou espirrar sobre os alimentos, uso
de panos (de prato ou outros na cozinha) contaminados.
Sintomas da doen?a: v?mito intenso, mal estar, dor de cabe?a,
raramente diarr?ia, sem febre.
Per?odo de incuba??o: 1 a 6 horas.
Principais alimentos onde podem estar presentes: alimentos com alta
concentra??o de a?car (doces cremosos) e sal (bacalhau, feijoada), leite,
queijo, batatas (manipula??o e armazenagem inadequada).
Temperatura de destrui??o: esse microorganismo ? capaz de produzir
esporos resistentes ao calor, o que dificulta sua destrui??o.
|
|
|
Clostridium perfringens:
 Habitat: fezes de animais, solo, poeira, hortali?as e temperos
Habitat: fezes de animais, solo, poeira, hortali?as e temperos
Contamina??o: contato com o solo atrav?s dos produtos in natura
(verduras, legumes etc) antes de serem completamente higienizados, m?os mal
lavadas que estiveram em contato com terra ou produtos in natura como os
descritos, superf?cies da cozinha que estiveram em contato com os mesmos
materiais. Nesse caso, um alimento cru (exemplo: verdura) pode contaminar um
alimento cozido (exemplo: carne assada) quando colocados em uma mesma
vasilha sem a higieniza??o correta.
Sintomas da doen?a: c?licas abdominais, diarr?ia, n?useas, raramente
v?mito, sem febre.
Per?odo de incuba??o: 8 a 22 horas.
Principais alimentos onde podem estar presentes: alimentos prot?icos
como carnes cozidas, assados, feij?o, molhos de carne, alimentos cozidos ou
refogados armazenados por v?rias horas em temperatura inadequada.
Temperatura de destrui??o: esse microorganismo ? capaz de produzir
esporos resistentes ao calor, o que dificulta sua destrui??o.
|
|
 Bacillus cereus cl?ssico::
Bacillus cereus cl?ssico::
Habitat: solo, cereais, gr?os, vegetais
Contamina??o: contato com o solo atrav?s dos produtos in natura
(verduras, legumes etc) antes de serem completamente higienizados, m?os mal
lavadas que estiveram em contato com terra ou produtos in natura como os
descritos, superf?cies da cozinha que estiveram em contato com os mesmos
materiais. Nesse caso, um alimento cru (exemplo: verdura) pode contaminar um
alimento cozido (exemplo: carne assada) quando colocados em uma mesma
vasilha sem a higieniza??o correta.
Sintomas da doen?a: diarr?ia, n?useas, raramente v?mito, sem febre.
Per?odo de incuba??o: 8 a 22 horas.
Principais alimentos onde podem estar presentes: arroz e feij?o
cozidos, arroz doce, canjica, verduras cozidas (armazenagem em temperatura
inadequada).
Temperatura de destrui??o: esse microorganismo ? capaz de produzir
esporos resistentes ao calor, o que dificulta sua destrui??o.
|
|
|
Escherichia coli:
 Habitat: fezes do homem e de animais, ?gua de rios, lagos e po?os.
Habitat: fezes do homem e de animais, ?gua de rios, lagos e po?os.
Contamina??o: indica contamina??o atrav?s de fezes (contamina??o
fecal).
Sintomas da doen?a: diarr?ia, mal estar, c?licas.
Per?odo de incuba??o: 8 a 22 horas
Principais alimentos onde podem estar presentes: ?gua, hortali?as,
carnes, aves e pescados crus ou mal cozidos, lasanha, sobremesas (alimentos
processados de forma manual, mal cozidos ou mantidos em temperatura
inadequada).
Temperatura de destrui??o: 60? C
|
|
|
Salmonella sp:
 Habitat: intestinos do homem e de animais, alimentos de origem
animal, gema de ovo.
Habitat: intestinos do homem e de animais, alimentos de origem
animal, gema de ovo.
Contamina??o: cozimento inadequado de alimentos.
Sintomas da doen?a: diarr?ia, mal estar, c?licas, febre, v?mitos.
Per?odo de incuba??o: 8 a 22 horas.
Principais alimentos onde podem estar presentes: maionese, aves e
carnes, frutos do mar, gema de ovo (alimentos mal cozidos ou mantidos em
temperatura inadequada).
Temperatura de destrui??o: 60? C por 15 minutos.
|
|
|
Shigella:
 Habitat: intestinos do homem e m?os contaminadas.
Habitat: intestinos do homem e m?os contaminadas.
Contamina??o: ?gua de po?o, m?os mal lavadas.
Sintomas da doen?a: disenteria, c?licas, febre, v?mitos.
Per?odo de incuba??o: 12 a 72 horas.
Principais alimentos onde podem estar presentes: produtos c?rneos,
l?cteos e verduras.
Temperatura de destrui??o: 60? C por 15 minutos.
|
|
|
Vibrio parahaemolyticus:
:
 Habitat: ?gua salgada.
Habitat: ?gua salgada.
Contamina??o: armazenagem sob temperatura insuficiente, aus?ncia de
coc??o.
Sintomas da doen?a: n?usea, diarr?ia, febre, v?mitos.
Per?odo de incuba??o: 12 a 18 horas.
Principais alimentos onde podem estar presentes: pescados e mariscos
crus.
Temperatura de destrui??o: 60? C por 15 minutos.
|
|
|
Clostridium botulinum
:
 Habitat: solo, ?gua, vegetais, pescados.
Habitat: solo, ?gua, vegetais, pescados.
Contamina??o: alimentos cozidos deixados em temperatura inadequada
por v?rias horas, condi?es de anaerobiose, ou seja, aus?ncia de
oxig?nio.
Sintomas da doen?a: vis?o dupla, dificuldade de falar, engolir e
respirar, insufici?ncia respirat?ria, podendo levar ? morte.
Per?odo de incuba??o: 8 a 36 horas.
Principais alimentos onde podem estar presentes: embutidos n?o
refrigerados (defumados), enlatados mal processados, conservas caseiras,
pescados.
Temperatura de destrui??o: 100? C por 15 minutos.
|
|
* Colabora??o: M?rcia Regina da Silva.
Cristina Garcia Lopes
? nutricionista formada
pela Universidade Federal de Vi?osa.
Saiba mais
clicando aqui.
Sobre quais temas (da ?rea de nutri??o) voc? quer ler novos artigos
nesta se??o? A nutricionista Cristina Lopes aguarda suas sugest?es no e-mail
nutricao@jfservice.com.br

 Habitat: pele, nariz, garganta, cabelo, ferida com pus e espinhas.
Contamina??o: m?os n?o lavadas, tossir ou espirrar sobre os alimentos, uso
de panos (de prato ou outros na cozinha) contaminados.
Habitat: pele, nariz, garganta, cabelo, ferida com pus e espinhas.
Contamina??o: m?os n?o lavadas, tossir ou espirrar sobre os alimentos, uso
de panos (de prato ou outros na cozinha) contaminados. Habitat: fezes de animais, solo, poeira, hortali?as e temperos
Habitat: fezes de animais, solo, poeira, hortali?as e temperos Bacillus cereus cl?ssico::
Bacillus cereus cl?ssico:: Habitat: fezes do homem e de animais, ?gua de rios, lagos e po?os.
Habitat: fezes do homem e de animais, ?gua de rios, lagos e po?os. Habitat: intestinos do homem e de animais, alimentos de origem
animal, gema de ovo.
Habitat: intestinos do homem e de animais, alimentos de origem
animal, gema de ovo. Habitat: intestinos do homem e m?os contaminadas.
Habitat: intestinos do homem e m?os contaminadas. Habitat: ?gua salgada.
Habitat: ?gua salgada. Habitat: solo, ?gua, vegetais, pescados.
Habitat: solo, ?gua, vegetais, pescados.